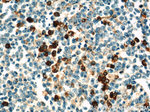
IL-6 Antibody in Immunohistochemistry (Paraffin) (IHC (P))

Search
Proteintech
IL-6 Polyclonal Antibody
{{$productOrderCtrl.translations['antibody.pdp.commerceCard.promotion.promotions']}}
{{$productOrderCtrl.translations['antibody.pdp.commerceCard.promotion.viewpromo']}}
{{$productOrderCtrl.translations['antibody.pdp.commerceCard.promotion.promocode']}}: {{promo.promoCode}} {{promo.promoTitle}} {{promo.promoDescription}}. {{$productOrderCtrl.translations['antibody.pdp.commerceCard.promotion.learnmore']}}
产品信息
21865-1-AP
种属反应
已发表种属
宿主/亚型
分类
类型
抗原
偶联物
形式
浓度
规格
纯化类型
保存液
内含物
保存条件
运输条件
产品详细信息
Immunogen sequence: MNSFSTSAF GPVAFSLGLL LVLPAAFPAP VPPGEDSKDV AAPHRQPLTS SERIDKQIRY ILDGISALRK ETCNKSNMCE SSKEALAENN LNLPKMAEKD GCFQSGFNEE TCLVKIITGL LEFEVYLEYL QNRFESSEEQ ARAVQMSTKV LIQFLQKKAK NLDAITTPDP TTNASLLTKL QAQNQWLQDM TTHLILRSFK EFLQSSLRAL RQM (1-212 aa encoded by BC015511)
靶标信息
IL-6 is a gene that encodes a cytokine that plays a role in inflammation and the maturation of B cells. The protein produced by this gene is an endogenous pyrogen that can induce fever in people with autoimmune diseases or infections. The gene is primarily expressed at sites of acute and chronic inflammation, where it is secreted into the serum and induces a transcriptional inflammatory response through interleukin 6 receptor, alpha. The functioning of this gene is implicated in a wide variety of inflammation-associated disease states, including suspectibility to diabetes mellitus and systemic juvenile rheumatoid arthritis. Elevated levels of the encoded protein have been found in virus infections, including COVID-19 (disease caused by SARS-CoV-2). Diseases associated with IL6 include Kaposi Sarcoma and Rheumatoid Arthritis, Systemic Juvenile.
仅用于科研。不用于诊断过程。未经明确授权不得转售。
生物信息学
蛋白别名: B-cell differentiation factor; B-cell stimulatory factor 2; BSF-2; CDF; CTL differentiation factor; H-IL-6; Hybridoma growth factor; hybridoma growth factor peptide; IFN-beta-2; IL-6; IL6; ILN; interferon 6 precursor; Interferon beta-2; Interleukin; interleukin 6; interleukin BSF-2; Interleukin-6; Interleukin6; M-IL-6; R-IL-6; unnamed protein product
基因别名: BSF-2; BSF2; CDF; HGF; HSF; IFN-beta-2; IFNB2; IL-6; IL6
UniProt ID: (Human) P05231
Entrez Gene ID: (Human) 3569